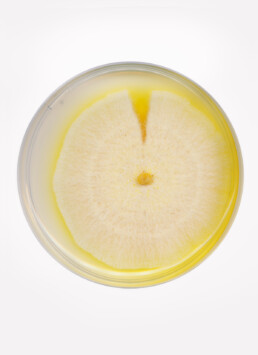
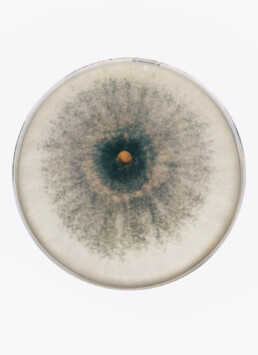
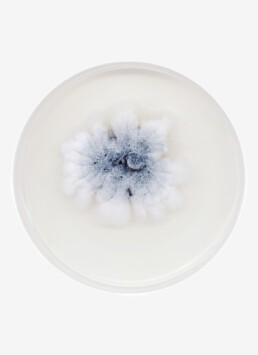

The Danish artist photographer Nicolai Howalt practises what could be called a highlighting technique. Explorer of the incomprehensible, of facets of human life which escape us either due to their scale or their invisibility, the artist takes an experimental, serial approach to capture, to make visible, or to simply expose the questions raised by his subject. Method and random meet: Nicolai Howalt’s positioning is humble and filled with doubt. He does not impose us anything, but rather shows us a world where humans stand small next to nature and a temporality beyond them. His work often comes with exchanges with scientists, materialised in texts published in his books.
F.U.N.G.I. places itself at the crossroads between science and art and raises issues of existential ecology and of phenomenology of time and of the image. This body of works aims at stimulating the imagination, at awakening consciousness and reflexions on the mysterious but vital presence of fungi in our life and our environment. F.U.N.G.I. questions our complex relationship to that nature with which we interact, whilst inviting us to question the physicality and history of photography.
In pictures
Agenda
SIGNATURE
Nicolai HOWALT signs Fungi (Fabrikbooks, 2025, Copenhagen) published for the show.
48 rue de Turenne, Paris 3e
TALK
Nicolai HOWALT in conversation with art critic and AICA PRIZE winner 2024 Clémentine MERCIER
48 rue de Turenne, Paris 3e
DIMANCHE D'OUVERTURE
Holiday Selection by Maria Lund
Featuring beloved independent makers & exclusive creations by our artists
More details coming soon
LUXEMBOURG ART WEEK
'a room for conversation'
Peter Martensen - Min Jung-Yeon - Bente Skjøkttgaard - Yoo Hye-Sook
Glacis Square (Fouerplaatz) L-1628 Luxembourg